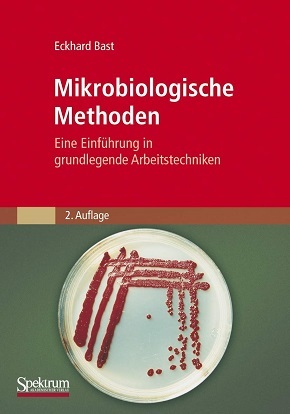

22,69 MB – pdf
Beschreibung:
Mikroorganismen sind wichtige Objekte der Forschung und Werkzeuge der Gentechnologie. Sie stellen nĂĽtzliche Helfer in Landwirtschaft und Industrie und bei der Mineralisation von Abfall- und Schadstoffen dar. Sie verursachen jedoch auch Krankheiten, den Verderb von Lebensmitteln und die Zersetzung von Werkstoffen. Die Beschäftigung mit ihnen und ihren unterschiedlichen Aktivitäten setzt die Kenntnis grundlegender mikrobiologischer Methoden voraus. Genau diese vermittelt das vorliegende Buch, leicht verständlich und praxisnah. Das Buch richtet sich an Studierende und Dozenten der Biologie, Biotechnologie und Medizin, an Biologielehrer, an technische Assistenten und an Wissenschaftler in Forschung, Industrie und Untersuchungslabors. Es bietet · präzise und reproduzierbare “Man-nehme”-Vorschriften der wichtigsten mikrobiologischen Methoden · die theoretischen Grundlagen und Hinweise zur Auswertung, zur Leistungsfähigkeit und zu den Grenzen der behandelten Arbeitstechniken · Erläuterungen zu Bau und Funktion der benötigten Geräte und zu den Eigenschaften der eingesetzten Materialien sowie ein ausfĂĽhrliches Bezugsquellenverzeichnis · eine Beschreibung der gebräuchlichen Sterilisationsverfahren und des sterilen Arbeitens · wichtige Informationen zu Nährböden und Kulturgefäßen · Anleitungen zur Anreicherung, Isolierung und Kultivierung einzelliger Mikroorganismen · Angaben zur Beschaffung und Aufbewahrung von Reinkulturen · eine Darstellung lichtmikroskopischer Untersuchungsverfahren und Färbetechniken · einen Ăśberblick ĂĽber Methoden der Zellzahl- und Biomassebestimmung bei Bakterien und Hefen. Dieses Buch wird sich bald als unentbehrlicher Begleiter fĂĽr alle erweisen, die erste Erfahrungen im Umgang mit Mikroorganismen, insbesondere mit Bakterien, sammeln oder sich ĂĽber die gängigen Standardmethoden informieren wollen oder Arbeitsunterlagen fĂĽr die praktische mikrobiologische Ausbildung suchen. FĂĽr die 2. Auflage wurde der Text durchgesehen und das Literaturverzeichnis auf den neuesten Stand gebracht. Druckfehler wurden korrigiert, kleinere Ergänzungen vorgenommen, Adressen, Bakteriennamen sowie gesetzliche Bestimmungen wurden aktualisiert.

Blog-Ansicht
Gallery-Ansicht

{ 0 comments… add one }